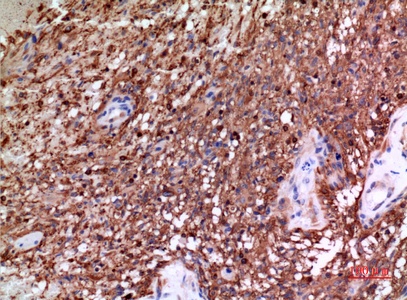
Fig.3. Immunohistochemical analysis of paraffin-embedded human-brain, antibody was diluted at 1:100.

| Product name | Tubulin α Polyclonal Antibody |
| Immunogen | Synthesized peptide derived from human Tubulin α around the non-acetylation site of K40 |
| Host | Rabbit |
| Reactivity | Human,Mouse,Rat |
| Applications | WB,IHC,IF,ELISA |
| Applications notes | Optimal working dilutions should be determined experimentally by the investigator. Suggested starting dilutions are as follows: WB 1:500-1:2000;IHC: 1:100-1:300;ELISA 1:20000;IF 1:50-200 |
| Clonality | Polyclonal |
| Preparation method | The antibody was affinity-purified from rabbit antiserum by affinity-chromatography using epitope-specific immunogen. |
| Alternative | TUBA1A; TUBA3; Tubulin alpha-1A chain; Alpha-tubulin 3; Tubulin B-alpha-1; Tubulin alpha-3 chain; TUBA1B; Tubulin alpha-1B chain; Alpha-tubulin ubiquitous; Tubulin K-alpha-1; Tubulin alpha-ubiquitous chain; TUBA1C; TUBA6; Tubulin alpha-1C chain; Alpha-tubulin 6; Tubulin alpha-6 chain; TUBA3C; TUBA2; TUBA3D; Tubulin alpha-3C/D chain; Alpha-tubulin 2; Alpha-tubulin 3C/D; Tubulin alpha-2 chain; TUBA4A; TUBA1; Tubulin alpha-4A chain; Alpha-tubulin 1; |
| Formulation | Liquid solution |
| Concentration | 1 mg/ml |
| Molecular weight | 50kD |
| Storage buffer | Liquid in PBS containing 50% glycerol, 0.5% BSA and 0.02% sodium azide. |
| Storage instructions | Stable for one year at -20°C from date of shipment. For maximum recovery of product, centrifuge the original vial after thawing and prior to removing the cap. Aliquot to avoid repeated freezing and thawing. |
| Shipping | Gel pack with blue ice. |
| Precautions | The product listed herein is for research use only and is not intended for use in human or clinical diagnosis. Suggested applications of our products are not recommendations to use our products in violation of any patent or as a license. We cannot be responsible for patent infringements or other violations that may occur with the use of this product. |
| Background | Microtubules of the eukaryotic cytoskeleton perform essential and diverse functions and are composed of a heterodimer of alpha and beta tubulins. The genes encoding these microtubule constituents belong to the tubulin superfamily, which is composed of six distinct families. Genes from the alpha, beta and gamma tubulin families are found in all eukaryotes. The alpha and beta tubulins represent the major components of microtubules, while gamma tubulin plays a critical role in the nucleation of microtubule assembly. There are multiple alpha and beta tubulin genes, which are highly conserved among species. This gene encodes alpha tubulin and is highly similar to the mouse and rat Tuba1 genes. Northern blotting studies have shown that the gene expression is predominantly found in morphologically differentiated neurologic cells. This gene is one of three alpha-tubulin genes in a cluster on chromosome 12q. Mutations in this gene cause lissencephaly type 3 (LIS3) - a neurological condition characterized by microcephaly, mental retardation, and early-onset epilepsy and caused by defective neuronal migration. Alternative splicing results in multiple transcript variants encoding distinct isoforms. |
| Gene ID | 7846 |
| Alternative | TUBA1A; TUBA3; Tubulin alpha-1A chain; Alpha-tubulin 3; Tubulin B-alpha-1; Tubulin alpha-3 chain; TUBA1B; Tubulin alpha-1B chain; Alpha-tubulin ubiquitous; Tubulin K-alpha-1; Tubulin alpha-ubiquitous chain; TUBA1C; TUBA6; Tubulin alpha-1C chain; Alpha-tubulin 6; Tubulin alpha-6 chain; TUBA3C; TUBA2; TUBA3D; Tubulin alpha-3C/D chain; Alpha-tubulin 2; Alpha-tubulin 3C/D; Tubulin alpha-2 chain; TUBA4A; TUBA1; Tubulin alpha-4A chain; Alpha-tubulin 1; |
| Others | Tubulin α Polyclonal Antibody detects endogenous levels of Tubulin α protein. |
| Accession | Q71U36 |
| Observed Band(KD) | 50 |

Fig.1. Western Blot analysis of Jurkat cells using Tubulin α Polyclonal Antibody. Antibody was diluted at 1:1000. Secondary antibody (catalog#: A21020) was diluted at 1:20000.

Fig.2. Immunohistochemical analysis of paraffin-embedded human-brain, antibody was diluted at 1:100.
Fig.3. Immunohistochemical analysis of paraffin-embedded human-brain, antibody was diluted at 1:100.
You must be logged in to post a review.
Reviews
There are no reviews yet.